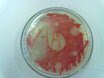

Morphological Characteristics
Cell shape: Bacilli
Size: Small
Spores: none
Gram's Stain: Negative
Motility: Motile
Capsules: none
Special stains: Acid-fast
Cultural Characteristics
Colonies: red
Nutrient agar: red
Blood agar: white, partial lysis
Agar slant: red
Nutrient broth: pink
Gelatin slab: turbid
Oxygen requirements: facultative anaerobe
Optimum temperature: 25 degrees Celsius (but varies, also grows well at 37 degrees Celsius)
Physiological Characteristics
Fermentation
- Glucose: positive
- Lactose: partial
- Sucrose: positive
- Mannitol: negative
- Gelatin liquefaction: positive
- Starch: negative
- Casein: partial
- Fat: positive
- Indole: positive
- Methyl Red: negative
- Voges-Proskauer (acetylmethylcarbinol): positive
- Citrate Utilization: positive
- Nitrate Utilization: positive
- Urease: negative
- Oxidase: positive
- Acid: no pH change
- Alkaline: no pH change
- Coagulation: soft curd formed